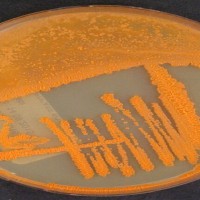

تحضر مجموعة كبيرة من النجوم على السجادة الحمراء للمشاركة في احتفال توزيع جوائز «غرامي»، التي تُعدّ الأهم بين مكافآت الصناعة الموسيقية الأميركية، وأبرزها المغنيتان بيونسيه وأديل، اللتان حصلتا على أكبر عدد من الترشيحات.
كذلك يُعدّ كندريك لامار وهاري ستايلز وتايلور سويفت من بين الأوفر حظاً في هذا الاحتفال الخامس والستين، الذي يجمع عدداً كبيراً من الفنانين المشهورين، من بينهم باد باني وليزو وستيف لايسي وماري جي بلايج.
وتتصدر قائمة الترشيحات هذه السنة نجمة البوب بيونسيه في تسع فئات، ثم مغني الراب كندريك لامار بثمانية ترشيحات. أما البريطانية أديل ونجمة موسيقى الفولك الأميركية، وروك براندي كارلايل، فلكل منهما سبعة ترشيحات.
وهذا الاحتفال الذي يقدمه الممثل الكوميدي تريفور نوا، وهو بالنسبة للموسيقى بمنزلة جوائز الأوسكار سينمائياً، يتوج سنة حافلة بالألبومات التي حققت نجاحاً كبيراً، ومنها «رينيسانس» لبيونسيه و«30» لأديل، حسب تقرير وكالة الصحافة الفرنسية.
وسيكون الألبومان في تنافس مباشر وجهاً لوجه في الفئات الأبرز، بعد ست سنوات من مواجهة انتهت لصالح أديل. ففي عام 2017. اكتسحت الفنانة البريطانية المنافسة في الفئات الرئيسية، وفازت بخمس جوائز مع ألبومها «25»، على حساب المغنية المولودة في هيوستن التي اكتفت بجائزة أفضل ألبوم للموسيقى الحضرية المعاصرة مع ألبومها «ليمونادا»، الذي أصبح من الكلاسيكيات. وعلى خشبة المسرح خلال الحفلة حينها، أشادت أديل بـ«الملكة» بيونسيه، فيما اتُهمت «ريكوردينغ أكاديمي»، القائمة على جوائز «غرامي» مجدداً بالتمييز ضد الفنانين ذوي البشرة الملونة.
وتوقعت مجلة «بيلبورد» المتخصصة أن تكون جائزة «غرامي» لأفضل ألبوم من نصيب بيونسيه، وأن تفوز أديل بجائزة «أفضل أغنية للعام» مع «إيزي أون مي». إلا أن مفاجآت السنوات السابقة تدعو إلى محاذرة الجزم بالنتائج سلفاً. وسواء أفازت بيونسيه أو لم تفز، فهي باتت صاحبة إنجازات وأرقام قياسية، إذ إنها، مع الترشيحات الجديدة، باتت كزوجها مغني الراب جاي زي، أكثر الفنانين نيلاً للترشيحات على الإطلاق، مع 88 ترشيحاً.
وقد لا تعود بيونسيه بعد الاحتفال الأكثر فوزاً بجوائز «غرامي» بين الإناث فحسب، بل قد تتبوأ المرتبة الأولى بين الفائزين من الجنسين، محطمة رقم قائد الأوركسترا الشهير جورج شولتي لأكبر عدد من الجوائز.وكالات
موجة برد قطبي تضرب شمال شرقي الولايات المتحدة وكندا
كثّفت خدمات الأرصاد الجوية في كل من الولايات المتحدة وكندا تحذيراتها في مواجهة درجات حرارة قطبية، قد تصل إلى 50 درجة تحت الصفر، في شمال شرقي الولايات المتحدة وشرق كندا؛ حيث تجتاحهما رياح جليدية.
وشهدت ولاية ماين في شمال الولايات المتحدة؛ خصوصاً ليل الجمعة- السبت الماضيين انخفاضاً شديداً في درجة الحرارة إلى 51 درجة تحت الصفر، وفقاً لنشرة صادرة عن مصلحة الأرصاد الجوية الوطنية لمنطقة كاريبو القريبة من الحدود مع كندا.
وقالت مصلحة الأرصاد الجوية الوطنية لمنطقة كاريبو: «إنه برد قطبي تاريخي» غير مسبوق على نطاق «جيل كامل»، وهو «شيء لم يشهده -خصوصاً- شمال ولاية ماين وشرقها منذ عامَي 1982 و1988».
وأشارت إلى أنه في أجزاء من شمال شرقي الولايات المتحدة وهذه المنطقة من نيو إنغلاند، قد تصل درجات الحرارة تحت تأثير رياح جليدية «إلى أدنى مستوياتها منذ عقود، أو حتى إلى مستوى غير مسبوق بتاتاً»، حسب تقرير وكالة «الصحافة الفرنسية».
على الجانب الآخر من الحدود، أُصدرت تحذيرات من برد قطبي في شرق كندا، وفقاً لوزارة البيئة التي أشارت إلى خطر الإصابة بقضمة صقيع في غضون دقائق.
وبلغت درجة الحرارة 41 تحت الصفر في مونتريال، بعد ظهر الجمعة. وقد تنخفض إلى -50 درجة في المناطق الشمالية من كيبيك. وتصاعد دخان أبيض، يعرف بـ«دخان بحار المنطقة القطبية الجنوبية» فوق نهر سان لوران، بسبب البرد القارس الذي يمر فوق المياه غير المتجمدة.
أما في مونتريال، فضربت رياح قوية المارة القلائل في وسط المدينة.
وفي العاصمة أوتاوا، كانت الرؤية شبه معدومة ليل الخميس- الجمعة، بسبب تساقط الثلوج التي صاحبتها رياح قوية.وكالات
نيويورك تعيد 14 قطعة أثرية مسروقة إلى روما
أعادت نيويورك 14 قطعة أثرية إلى إيطاليا تُقدّر قيمتها بنحو 2.5 مليون دولار، في إطار تحقيق جنائي في تهريب قطع أثرية مسروقة، حسب وكالة الصحافة الفرنسية.
وخلال العامين الماضيين، نفّذ مكتب المدعي العام لمقاطعة مانهاتن، حملة واسعة لاستعادة الآثار المنهوبة التي انتهى بها المطاف في المتاحف والمعارض في نيويورك، بما يشمل متحف متروبوليتان الفني العريق.
خلال مراسم أقيمت بحضور القنصل العام الإيطالي وممثلين عن الشرطة الإيطالية، سلمت 14 قطعة أثرية يعود بعضها إلى نحو 2600 عام، إلى إيطاليا، ليصل العدد الإجمالي للقطع التي أعيدت إلى هذا البلد خلال الأشهر السبعة الماضية إلى 214، وفق مكتب المدعي العام في المقاطعة ألفين براغ.
وفي بيان، أشار مكتب براغ إلى أن أكثر من 700 قطعة تزيد قيمتها على 100 مليون دولار أعيدت العام الماضي إلى 17 دولة، من بينها كمبوديا والهند وباكستان ومصر والعراق واليونان وإيطاليا.
وأنشأت نيويورك، وهي مركز للاتجار بالآثار المسروقة منذ عقود، فريق عمل في عام 2017 للتحقيق في هذه الأنشطة غير القانونية.
وبحسب بيان المدعي العام براغ الذي تسلّم منصبه في يناير 2022، شملت القطع المعادة ، عملة فضية تُعرف باسم «عملة صقلية ناكسوس» تم سكها بحدود عام 430 قبل الميلاد وتبلغ قيمتها حالياً نصف مليون دولار.
ومن بين القطع البارزة الأخرى، فخار قديم يعود تاريخه إلى عام 510 قبل الميلاد، ورأس من الرخام للإمبراطور الروماني هادريان يعود تاريخه إلى عام 200 ميلادياً.
ولفت البيان إلى أن من بين الضالعين في الاتجار بالقطع الـ14 المعادة، مهربي القطع الفنية المشهورين جاكومو ميديتشي وجوفاني فرانكو بيكينا، وكذلك روبرت هيكت، وهو أميركي كان يقيم في باريس وتوفي في عام 2012.
وأضاف البيان أن المهربين «اعتمدوا على عصابات من نابشي القبور لنهب مواقع أثرية مختارة بعناية وغير خاضعة لحراسة كافية في جميع أنحاء منطقة المتوسط.وكالات
أنواع الفراشات في بريطانيا انخفضت 80 % منذ عام 1970
كشف تقرير جديد عن أن أنواع الفراشات في المملكة المتحدة انخفضت إلى نحو 80 % منذ السبعينات، حسب صحيفة «الإندبندنت» البريطانية.
وقال علماء في الجمعية الخيرية للحفاظ على الفراشات للحياة البرية، الذين أصدروا تقريراً عن حالة الفراشات في المملكة المتحدة لعام 2022، إن انخفاض الحشرات الملونة يشير إلى أزمة أوسع نطاقاً في التنوع البيولوجي.
وباستخدام البيانات التي جمعها المتطوعون في جميع أنحاء البلد، قاس العلماء وفرة الفراشات وتوزيعها، ووجدوا أن فراشات الموائل المعينة، مثل تلك التي تعتمد على الأراضي العشبية الغنية بالزهور، والأراضي الرطبة، والأراضي المشجرة، قد انخفضت بنسبة 27 في المائة، واختفت من ثلثي المنطقة التي كانت تحتلها في عام 1976.
أما الأنواع الأخرى القادرة على التكاثر في البيئات الحضرية أو المزارع فقد كانت أكثر قدرة على الصمود، لكنها كمجموعة ما زالت تنخفض بنسبة 17 في المائة من حيث الأعداد، وبنسبة 8 في المائة من حيث التوزيع.
كما أظهرت البيانات أن بعض أنواع الفراشات الجنوبية تنتشر شمالاً مع المناخ الدافئ. وقد زاد نطاق توزيع فراشات «الفاصلة» بنسبة 94 في المائة منذ عام 1976، بينما زاد تعدادها بنسبة 203 في المائة.
ولكن تبين أن معظم الأنواع مُقيدة بالتغيرات المناخية، وكذلك بعوامل بشرية أخرى مثل الزراعة، والتنمية الحضرية، والتلوث.
وتُصنف «جمعية حماية الفراشات» نصف الأنواع المتبقية من الفراشات في المملكة المتحدة بأنها مُهددة أو قريبة من التهديد، وأدرجتها على قائمة حمراء من الأنواع المعرضة للخطر.
وقال الدكتور ريتشارد فوكس، كبير مؤلفي التقرير، «إذا كانت الفراشات قد اختفت، فإننا لن نلاحظ أي آثار فورية هائلة. لكن هذا ليس هو المقصود .وكالات
الأطفال يتذكرون الوجوه رغم وضع الأقنعة
يتعلم الأطفال من النظر إلى الوجوه البشرية، ما دفع العديد من الآباء وخبراء الطفولة إلى القلق على نطاق واسع في أثناء انتشار وباء (كوفيد – 19)، بشأن الضرر المحتمل الناجم عن إخفاء الوجه.
وقللت دراسة جديدة أجراها باحثون في جامعة كاليفورنيا الأميركية هذه المخاوف، حيث وجدت الدراسة المنشورة في العدد الأخير من دورية «الطفولة»، أن الأطفال الذين تتراوح أعمارهم بين 6 و9 أشهر، يمكنهم تكوين ذكريات عن الوجوه المقنّعة والتعرف على تلك الوجوه عند الكشف عنها.
واستخدمت ميكايلا ديبولت، طالبة الدكتوراه في علم النفس المعرفي، وليزا أوكس، الأستاذة في قسم علم النفس بمركز العقل والدماغ بجامعة كاليفورنيا، تَتَبُّعَ العين لدراسة كيفية تأثير الأقنعة في قدرة الأطفال على التعرف على الوجوه. ووجدت ديبولت وأوكس أن «لدى الأطفال قدرات عالية على التكيف مع مشاهدة أمهاتهم يضعون القناع».
وفي الدراسة نفسها، تم عرض أزواج من وجوه النساء المقنّعة وغير المقنّعة على شاشة الكومبيوتر لـ58 طفلاً، كل واحد منهم يجلس في حضن أحد الوالدين أو على كرسي مرتفع، بينما سجلت الكاميرات المكان الذي نظروا فيه.
وتقول ديبولت في تقرير نشره الموقع الإلكتروني لجامعة كاليفورنيا: «لأن الأطفال يقضون وقتاً أطول لتمييز الصور غير المألوفة، فإنه يمكن للباحثين استنباط الوجوه التي تعرفوا عليها، فعندما شاهد الأطفال وجهاً مقنّعاً، ثم شاهدوا ذلك الوجه نفسه مكشوفاً بعد ذلك، تعرفوا عليه».
ومع ذلك، عندما تم عكس الترتيب، لم يُظهر الأطفال تمييزاً قوياً للوجوه المقنّعة التي رأوها لأول مرة غير مقنّعة. وتضيف أن «ذلك كان مشابهاً لتجربتها الخاصة في عدم التعرف على الفور على صديق كان يرتدي قناعاً للوجه».
ورغم ما يبدو أنه أمر لا يستحق الاهتمام، تقول رنا حمدي، مدرس الطب النفسي، المتخصصة في الأطفال بجامعة الزقازيق (شمال شرقي القاهرة) لـ«الشرق الأوسط»: «تمييز الوجوه، هو أمر أساسي لكيفية تعلم الأطفال التحدث وإدراك المشاعر وتطوير العلاقات، لذلك كان هناك قلق من أن الجائحة وما تبعها من استخدام الأقنعة، قد يؤثر سلباً على الأطفال، ولكن نتائج الدراسة تبعث برسالة مطمئنة.وكالات
ثغرات أساسية في نظام «شات جي.تي.بي»
أصبحت منصة المحادثة الجديدة التي تعتمد على الذكاء الصناعي «شات جي.تي.بي»، التي أطلقتها شركة «أوبن إيه.آي» في أواخر العام الماضي، موضوع الحديث الأول في عالم تكنولوجيا المعلومات، بسبب قدرتها على تأليف الخطب ورواية القصص في ثوانٍ معدودة وبدقة بالغة اعتماداً على تقنيات الذكاء الصناعي.
لكن هذه المنصة أو البرنامج الذي تمت تغذيته بكميات ضخمة من البيانات حتى يتمكن من التفاعل مع المستخدم، ليس مثيراً للإعجاب فقط، وإنما للشكوك أيضاً.
وألقى علماء وخبراء تكنولوجيا المعلومات نظرة قريبة على برنامج «شات جي.تي.بي»، وبدأوا التحذير من بعض المشكلات الكبيرة، في مقدمتها حماية البيانات وثغرات أمن البيانات وبث خطابات الكراهية والأخبار الكاذبة.
تقول روث ستوك هامبورغ، مؤسسة مركز «ليب إن تايم لاب» للأبحاث في ألمانيا والأستاذة بجامعة دارمشتاد الفنية: «في هذه اللحظة يوجد كل هذا الضجيج… أشعر بأنه نادراً ما يتم النظر لهذا النظام بعين نقدية».
ويشير الخبراء إلى 4 ثغرات أساسية في نظام «شات جي.تي.بي»؛ أولاها إمكانية التلاعب فيه، حيث يعتمد نظام شات «جي.تي.بي» على مجموعة واسعة للغاية من التطبيقات. ومن خلال تجربة قام بها الباحثون في جامعة دارمشتاد الفنية من خلال قضاء 7 أسابيع في إرسال آلاف الأسئلة إلى نظام شات«جي.تي.بي»، اتضح أنه يمكن التلاعب به، بحسب ستوك هامبورغ.
أما المشكلة أو الثغرة الثانية فتتمثل في صعوبة تتبع مصادر المعلومات أو المحتوى في النظام. وأشارت ستوك هامبورغ إلى مثال عند توجيه أسئلة تحتوي على محتوى إجرامي، فإن هناك تعليمات وآليات أمنية للتعامل معها، لكن اتضح أنه يمكن الاحتيال على هذه الآليات بسهولة، بحسب طالب الدكتوراه وخبير لغة الذكاء الصناعي سفن شولتس.
وباستخدام طريقة أخرى يمكن جعل النظام يوضح كيفية إنتاج رسائل بريد إلكتروني احتيالية. كما يمكنه أن يشرح على الفور ثلاث طرق للاحتيال على كبار السن.
كما يمكن لنظام «شات جي.تي.بي» توضيح كيفية اقتحام المنازل، مع إرشادات مفيدة لكيفية استخدام الأسلحة في الاقتحام. في الوقت نفسه، لا يمكن تعقب مصادر هذا المحتوى الإجرامي عبر المنصة بسهولة.
المشكلة الثالثة تتمثل في المخاوف المتعلقة بحماية الخصوصية، حيث تظل المخاوف بشأن تأمين البيانات وحمايتها في كل تقنية جديدة.
وقالت كريستيان هولتاوس خبيرة حماية البيانات في فرنكفورت: «ما يمكن قوله هو أن شات جي.بي.تي يحصل على كم كبير ومتنوع من البيانات من المستخدمين ويقوم بتخزينها ومعالجتها، ثم وفي وقت محدد يقوم بإنشاء نموذج للمستخدم وفقاً لهذه البيانات»، مضيفة أن المشكلة تتمثل في وجود كل أجهزة كومبيوتر خادم هذا النظام بالولايات المتحدة، وهو ما يعطيها سيطرة غير مقبولة على بيانات المستخدمين من كل دول العالم.
وقالت هولتاوس: «هذه مشكلة فعلية إذا لم تنجحوا في تأسيس هذه التكنولوجيا بأوروبا أو تطوروا التكنولوجيا الخاصة بكم». وفي المستقبل القريب لن يكون هناك حل لضمان الالتزام بحماية البيانات.
أما المشكلة الرابعة فتتمثل في أن نظام «شات جي.تي.بي» ما زال غير ناضج وفي مرحلة التطور. وتقول ستوك هامبورغ إنه في هذه اللحظة ما زال الإقبال على النظام من جانب المستخدمين الأفراد، ولا يمثل شيئاً بالنسبة لقطاع الأعمال ولا المجالات ذات الصلة بأمن البيانات، مضيفة: «ليست لدينا فكرة عن كيفية التعامل مع هذا الشيء لأنه لم ينضج بعد.وكالات
طرق لفقدان الوزن باستخدام العسل
يمكن أن العسل مفيداً لفقدان الوزن، إذا تم استخدامه بشكل صحيح، حيث يساعد في تقليل الرغبة الشديدة في تناول الحلويات الأخرى، ويوفر العديد من الفيتامينات والمعادن ومضادات الأكسدة.
مع فوائده الصحية العديدة، يعتبر العسل بديلاً ممتازاً للسكريات المكررة لأولئك الذين يتطلعون إلى التحكم في وزنهم، ولكن من المهم استخدامه بشكل صحيح من أجل الحصول على أقصى استفادة من خصائصه الصحية.
فيما يلي 5 نصائح بسيطة لاستخدام العسل للتحكم في الوزن، وفق ما أوردت صحيفة تايمز أوف إنديا:
العسل مع دبس التوت
يساعد تناول العسل مع دبس التوت على إنقاص الوزن، كما تشير الدراسات إلى أن دبس التوت يمكن أن يساعد أيضاً في تحسين التمثيل الغذائي الذي يساهم في رفع مستويات الطاقة في الجسم طوال اليوم.
ويمكن للمرء أن يشرب العسل مع الماء الدافئ على معدة فارغة لتحفيز عملية التمثيل الغذائي، مما يساعد في تقليل الرغبة الشديدة في تناول الطعام، والتغلب على الجوع على مدار اليوم، وهذا يؤدي بدوره إلى تقليل استهلاك السعرات الحرارية بشكل عام.
تناول العسل كبديل للسكر
يحتوي العسل على سعرات حرارية أقل، وتساهم حلاوته المكثفة في جعله خياراً رائعاً لمن يسعون إلى إنقاص وزنهم، وهذا يعني أنه من خلال استبدال السكر بالعسل، من المحتمل أن ينتهي بك الأمر بتناول سعرات حرارية أقل مما هو عليه عند استخدام السكر العادي.يمكن استخدام العسل بدلاً من السكر المكرر في القهوة والحبوب والشاي وغيرها من المشروبات التي تحتاج إلى التحلية قبل الاستهلاك.
العسل يساعد في تسهيل الهضم
من المعروف على نطاق واسع أن العسل يعزز وظيفة الجهاز الهضمي، وذلك لاحتوائه على الإنزيمات التي تساعد في هضم الطعام عن طريق تكسير الكربوهيدرات الموجودة في الطعام، خاصة بعد تناول وجبة كبيرة. كما أنه يساعد في التخلص من الوزن الزائد الذي يتراكم في الجهاز الهضمي.
استخدامه قبل التمرين
يعمل العسل على تسريع مستويات الطاقة في الجسم، ويمكنك بذل المزيد من الجهد أثناء التمرين إذا كان لديك المزيد من الطاقة. لذلك يعد تناول العسل قبل وأثناء التمرين، طريقة رائعة لزيادة مستويات الطاقة لديك، مما يزيد من مقدرتك على ممارسة التمارين الرياضية بكثافة أعلى.
استخدام العسل لتخفيف الجوع
يحتوي العسل على وفرة من السكريات الطبيعية، والتي يمكن أن توفر الشعور بالشبع، وتقليل الرغبة الشديدة في تناول الوجبات الخفيفة غير الصحية. وبحسب الخبراء، فإن ملعقة من العسل يمكن أن تمنح الجسم الطاقة التي يحتاجها ليعمل دون التأثير على التوازن الغذائي.
أهمية توقيت تناول العسل
العسل غني بالفيتامينات والمعادن، وتعمل العناصر الغذائية الحية في العسل الخام على تعزيز قدرة الجسم على حرق الدهون عن طريق تسريع عملية التمثيل الغذائي. ومن أجل حرق المزيد من السعرات الحرارية، يُنصح بتناول العسل على الريق وقبل النوم مباشرة. تساعد المركبات المهمة في العسل في إنقاص الوزن عن طريق الحد من الشهية. لذلك فإن العسل هو أفضل غذاء لانقاص الوزن.وكالات
أدلة جديدة على أهمية علاج الضغط للحماية من الخرف
قال بحث جديد إن خفض ضغط الدم المرتفع يمكن أن يعيد تشكيل مسارات تطهير الدماغ، ما يقلل من خطر الإصابة بالخرف.
ومن المقرر عرض البحث خلال المؤتمر الدولي للسكتة الدماغية، والمنعقد في دالاس بين 8 و10 فبراير .
وبحسب “مديكال نيوز توداي”، استمرت فترة المتابعة في هذه الدراسة 4 سنوات تقريباً، وتم تقسيم المشاركين إلى مجموعتين، تلقت إحداهما علاجاً لخفض الضغط لأقل من 120 ملم/ زئبق، والثانية لأقل من 140 ملم/ زئبق.
وفي نهاية فترة المتابعة تم تصوير أدمغة المشاركين بالرنين المغناطيسي، لرصد المساحات المحيطة بالأوعية الدموية داخل الدماغ.
و”تحيط هذه المساحات بالشرايين والأوردة في المادة البيضاء العميقة داخل الدماغ، ويمكن أن تتضخم مع الشيخوخة أو الالتهاب أو اضطرابات إزالة الميالين أو عمليات التنكس العصبي التي تؤدي إلى الخرف”.
وتبين أن العلاج المكثف لضغط الدم يبطئ من تراكم كثافة المادة البيضاء داخل الدماغ، ويوفر وقاية أفضل من الخرف.وكالات
بريطانية يعرض عليها 246 ألف دولار لقص شعرها
ياسمين لارسن… فتاة عشرينية من مدينة بريستول البريطانية لقبها “رابنزول” لتميّزها بشعر طويل حريري يتجاوز المتر. وكشفت أنها تتلقى عروضاً مغرية لقصه مقابل بـ 246 ألف دولار وفقاً لما ذكرته لصحيفة ديلي ستار.
وذكرت أنها دخلت باب الشهرة بالصدفة، فلم تكن تتوقع أن جمال شعرها الطويل سيحولها إلى فتاة مؤثرة على مواقع التواصل ويتابعها نحو 100 ألف شخص على إنستغرام لمعرفة نصائحها حول العناية بالشعر.
وذكرت ياسمين لارسن (28 عاماً) خرّيجة الكيمياء الحيوية، أنّه لم يخطر ببالها أبداً أنْ تكون محط الأنظار، ولفتت إلى أنّها إضافة إلى المال، تلّقت عروضاً بالزواج، وهدايا مغرية مثل سيارة مرسيدس جديدة وشقة فاخرة.
وأوضحت أنّه إضافة إلى الجانب المُشرق، تتعرّض في كثير من الأحيان، لأشخاص يحبّون نشر كراهيتهم عبر الإنترنت، فيتّهمونها بالنرجسية والأنانية.
أما عن روتينها اليومي، فأعلنت عن أنّ المرّة الأخيرة التي قصّت فيها شعرها كانت عام 2017، وتستعمل حالياً زيت شعر طبيعي خالٍ من السيليكون، إضافة إلى علاج لفروة الرأس، ماسك الشعر.
وأوضحت أنّها تستخدم منشفة من الألياف الدقيقة، ومجفف شعر أيّوني، وفرشاة لفك تشابك الشعر، ومدلّك لفروة الرأس، مع غسل شعرها مرّة أو مرّتين في الأسبوع فقط.
وتعتبر أن شهرها هو “تاج جمالها”، وتقول: “العناية بشعري الطويل تستمر على مدار دوام كامل لكنها مجزية حيث تدل على الصحة والحكمة والأنوثة”.وكالات
بعض الأنواع من البكتيريا تأكل مواد بلاستيكية
أثبت علماء الأحياء الجزيئية الأوروبيون أن الميكروبات من فصيلة Rhodococcus ruber قادرة على تكسير البولي إيثيلين واستخدام جزيئات الهيدروكربون الناتجة عن ذلك في حياتها.
وقد تم نشر الدراسة بهذا الشأن في مجلة Marine Pollution Bulletin.
وقال، مايك غودريان، الباحث في المعهد الملكي الهولندي الخاص بدراسة البحر: “لأول مرة، تمكنا من إثبات أن الميكروبات قادرة على هضم البلاستيك الذي يتحلل إلى ثاني أكسيد الكربون وجزيئات أخرى. وسبق لزملائنا أن استعرضوا في الماضي أن هذه البكتيريا قادرة على تسريع تحلل المواد البلاستيكية، لكن للمرة الأولى أثبتنا أن هذه الكائنات الحية تستخدم منتجات تحلل البوليمرات في نشاط حياتها.”
يذكر إن تراكم كمية كبيرة من النفايات البلاستيكية في البيئة الطبيعية وفي مقالب القمامة يُجبر العلماء على البحث عن طرق كيميائية وبيولوجية للتخلص منها. وعلى سبيل المثال اكتشف علماء الأحياء الأوروبيون مؤخرا أن يرقات عثة الشمع يمكنها أكل وهضم أشكال مختلفة من البولي إيثيلين، واكتشف زملاؤهم اليابانيون الميكروبات التي يمكن أن تحلل الداكرون، وهو المادة الأكثر شيوعا في إنتاج الزجاجات والأواني البلاستيكية الأخرى.
ويدرس غودريان وزملاؤه على مدار أعوام كيفية تفاعل الميكروبات البحرية التابعة لأنواع Rhodococcus مع البلاستيك، وكيف إن تلك الميكروبات قادرة على تشكيل أغشية على سطح الجسيمات الدقيقة المصنوعة من البولي إيثيلين ومواد بوليمرية أخرى من صنع الإنسان تطفو في المحيط العالمي. وتسرع هذه الأغشية، كما اكتشف علماء المحيطات مؤخرا، من تحلل المواد البلاستيكية.
وقد اهتم علماء البيولوجيا الجزيئية الأوروبيون بما يحدث بالضبط عندما تتلامس الأغشية البكتيرية مع اللدائن الدقيقة. للإجابة على هذا السؤال، أعد الباحثون جزيئات البولي إيثيلين التي تحتوي على العديد من ذرات الكربون الـ13 الثقيلة. واستخدم العلماء ذراته لتتبع ما إذا كان البلاستيك القابل للتحلل قد دخل الميكروبات وما إذا كانت الميكروبات قد استخدمت نواتج تحلل البولي إيثيلين في حياتها.
ووضع الباحثون جزيئات من مادة البولي إيثيلين، التي تمت معالجتها بالأشعة فوق البنفسجية بغية محاكاة بقائها طويلاً في الماء، في وعاء به مستعمرات من ميكروبات Rhodococcus ruber وراقبوا كيف تغيرت نسبة الكربون الـ13 داخل الميكروبات وفي فضلاتها. وأظهرت الأرصاد اللاحقة أن الكربون الـ13 كان موجودا في كل من جزيئات ثاني أكسيد الكربون التي تنتجها الميكروبات وفي مكوّنات مختلفة من أغشية الخلايا.
يشير ذلك، حسب العلماء، إلى أن Rhodococcus ruber تحلل البلاستيك بنشاط وتستخدم مكوناته في حياتها. ووفقا لتقديرات العلماء الحالية، يمكن لهذه الميكروبات أن تدمّر ما يصل إلى 1.2٪ من إجمالي كتلة البولي إيثيلين التي تدخل المحيطات سنويا، إذا كانت الظروف البيئية مواتية لها.
وحسب غودريان وزملائه، فإن العلماء يخططون في المستقبل القريب لمتابعة تحلل البلاستيك بواسطة مستعمرات Rhodococcus ruber في الظروف البيئة الطبيعية. وخلص العلماء إلى أن فهم هذا الأمر هو ذو أهمية بالغة لتقييم كمية البلاستيك التي دمرّتها بكتيريا المحيطات منذ منتصف القرن الماضي.وكالات
جيمس ويب يلتقط مجرة حلزونية تبعد عن الأرض مليار سنة ضوئية بتفاصيل مذهلة
تاريخ النشر:03.02.2023 | 06:17 GMT | الفضاء
جيمس ويب يلتقط مجرة حلزونية تبعد عن الأرض مليار سنة ضوئية بتفاصيل مذهلة
تُظهر صورة تم إصدارها حديثا من تلسكوب جيمس ويب الفضائي التابع لناسا حقلا مزدحما من المجرات والنجوم، مع مجرة حلزونية بعيدة تبرز بتفاصيل مذهلة.
والمجرة الكبيرة المسماة LEDA 2046648، واضحة جدا في صورة تلسكوب جيمس ويب الفضائي (JWST) بحيث يمكن رؤية أذرعها الحلزونية الفردية.
ويعد هذا المستوى من التفاصيل أكثر إثارة للإعجاب بالنظر إلى أن المجرة المعنية تقع في كوكبة هرقل التي تبعد أكثر من مليار سنة ضوئية عن الأرض وعن التلسكوب.
وتُظهر الصورة أيضا مجموعة من المجرات والنجوم الأخرى، جميعها مميزة بشكل “مسامير الحيود” (diffraction spikes) سداسية الرؤوس والتي تُعد توقيعا لملاحظات تلسكوب جيمس ويب.
والتقطت الصورة بواسطة كاميرا جيمس ويب القريبة من الأشعة تحت الحمراء (NIRCam) بينما كان التلسكوب يراقب القزم الأبيض WD1657 + 343.
ويشار إلى أن المجرات الأخرى في الصورة ليست أصغر من LEDA 2046648 فحسب، بل إن بعضها أبعد أيضا، ما يوفر رؤية أعمق لتاريخ الكون، وهي إحدى الأهداف الرئيسية لجيمس ويب، الذي يراقبة المجرات البعيدة الواقع بعضها على مسافة أبعد بكثير من LEDA 2046648، من أجل النظر في الزمن إلى الكون عندما كان في مهده.
وهذه النظرة التاريخية ممكنة لأن الضوء يستغرق وقتا محدودا للسفر إلى الأرض من المجرات البعيدة، لذا فإن النظر إلى هذه المجرات يشبه رؤيتها في الوقت الذي غادر فيه الضوء، أحيانا في وقت مبكر من تاريخ 13.8 مليار سنة من بعد نحو 300 مليون سنة من الانفجار العظيم.
ومع ذلك، فإن الضوء الصادر من هذه المجرات لا يظل ثابتا على مدار رحلته التي استمرت عدة مليارات من السنين إلى المرآة الأساسية المطلية بالذهب والتي يبلغ عرضها 21 قدما (6.5 مترا) في جيمس ويب.
ويؤدي تمدد الكون إلى تمدد الأطوال الموجية لهذا الضوء، ما يقلل طاقته من الطيف المرئي إلى ضوء الأشعة تحت الحمراء.
وتُعرف هذه العملية باسم “الانزياح الأحمر”، حيث تنقل الضوء باتجاه النهاية الحمراء للطيف الكهرومغناطيسي.
وتجعل هذه الظاهرة قدرات اكتشاف الأشعة تحت الحمراء الخاصة بجيمس ويب مثالية لدراسة الضوء الأحمر المنبعث من المجرات القديمة، وبالتالي لتحديد تفاصيل تكوينها وتطورها وتكوينها.
ويمكن لعلماء الفلك بعد ذلك مقارنة بنية هذه المجرات القديمة البعيدة بتلك التي نراها أقرب إلى موطننا المجري، مجرة درب التبانة، الموجودة في حقبة أكثر حداثة من الكون.
ويمكن أن تساعد المقارنة في الكشف عن كيفية نمو المجرات لتشكيل البنية التي نراها في الكون اليوم.
بالإضافة إلى ذلك، يساعد الضوء القادم من المجرات البعيدة في الكشف عن تركيبها الكيميائي ، ويوضح لعلماء الفلك كيف ومتى تشكلت العناصر الثقيلة وكيف أصبحت أكثر وفرة في المجرات اللاحقة بفضل التخصيب من النجوم المتفجرة.وكالات